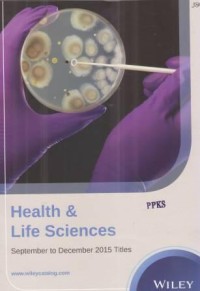

Hard Copy
Health & Life Sciences September to Desember 2015 Titles
Description Not Available
Availability
| M150186 | Pustaka PPKS Medan Lt. 1 (Rak Majalah) | Available |
Detail Information
- Series Title
-
-
- Call Number
-
-
- Publisher
- Sebastopol, CA : Wiley in Asia Pasific Region., 2015
- Collation
-
33p., illus., 29cm
- Language
-
English
- ISBN/ISSN
-
-
- Classification
-
-
- Content Type
-
-
- Media Type
-
-
- Carrier Type
-
-
- Edition
-
1
- Subject(s)
- Specific Detail Info
-
-
- Statement of Responsibility
-
-
Other version/related
No other version available
File Attachment
Comments
You must be logged in to post a comment
 Computer Science, Information & General Works
Computer Science, Information & General Works  Philosophy & Psychology
Philosophy & Psychology  Religion
Religion  Social Sciences
Social Sciences  Language
Language  Pure Science
Pure Science  Applied Sciences
Applied Sciences  Art & Recreation
Art & Recreation  Literature
Literature  History & Geography
History & Geography